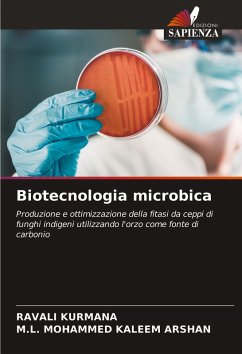

Presenza di cinque micotossine in cereali e prodotti a base di cereali
Versandkostenfrei!
Versandfertig in 1-2 Wochen
24,99 €
inkl. MwSt.

PAYBACK Punkte
12 °P sammeln!
Le micotossine sono metaboliti secondari delle muffe che hanno effetti negativi sull'uomo, sugli animali e sulle colture, con conseguenti malattie e perdite economiche. La contaminazione di alimenti e mangimi con micotossine rappresenta un problema significativo a livello mondiale. Zearalenone, Ocratossina A, Deossinivalenolo, T-2 e Aflatossina B1 sono le micotossine di maggiore importanza agroeconomica. I cereali rappresentano uno dei prodotti alimentari più importanti al mondo e sono molto sensibili agli attacchi fungini in campo e durante la conservazione. In questo libro viene esaminata e...
Le micotossine sono metaboliti secondari delle muffe che hanno effetti negativi sull'uomo, sugli animali e sulle colture, con conseguenti malattie e perdite economiche. La contaminazione di alimenti e mangimi con micotossine rappresenta un problema significativo a livello mondiale. Zearalenone, Ocratossina A, Deossinivalenolo, T-2 e Aflatossina B1 sono le micotossine di maggiore importanza agroeconomica. I cereali rappresentano uno dei prodotti alimentari più importanti al mondo e sono molto sensibili agli attacchi fungini in campo e durante la conservazione. In questo libro viene esaminata e discussa la presenza di cinque micotossine nei cereali e nei prodotti derivati.